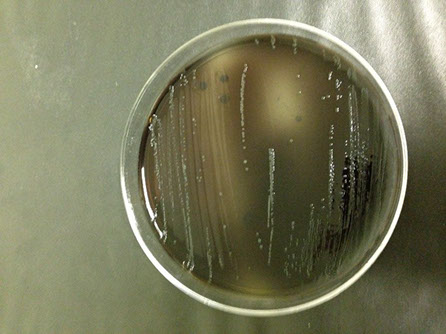

[row][column][textblock]
Volume 5 Issue 1
Katie Odrobina, Senior Consultant, Produce Food Safety[/textblock][textblock]
Listeria has been in the news lately as the culprit behind many food recalls from Blue Bell Creameries ice cream to pre-packaged caramel apples. But in practical terms what does it mean to your operation?
What Is It?
Listeria is a common bacteria found in soil. There are multiple species of listeria, but Listeria monocytogenes (L. mono) is the species of human concern. L. mono causes listeriosis which is characterized by fever, headache, stiffness, nausea, abdominal pain, diarrhea and in extreme cases may result in death.
Where Is It Found?
Listeria is found at the farm level in the soil, the water and possibly on the product itself. It is also found in the intestinal tracts of animals such as cattle.
Once introduced into the facility, listeria is quite happy to grow in cold, damp environments. While other pathogenic bacteria (E. coli and salmonella) can grow in cold storage, listeria is able to survive and flourish. Common areas listeria is found include, in drains, on walls and plastic strip curtains and in cracks and crevices of equipment.
Drains and drainage systems such as cooling units and their drip pans are danger areas. They provide an ideal growing environment for listeria.
Where Should I Test?
Any microbiological testing program is meant to be a tool. Testing locations should focus on verifying the efficacy of your cleaning/sanitizing program and the suitability of the environment and equipment. Keeping that in mind, common testing locations include:
- Drains (grates, surrounding area, etc.)
- Walls
- Plastic strip curtains
- Drip pans
- Cooling units
- Food contact line equipment (seams, brushes, sprayer nozzles, padding, etc.)
- Non-food contact line equipment (framework, joints, etc.)
Some laboratories also give the option of only screening for L. mono. This is not a good idea because it excludes any other type of listeria that may be present. This can cause false sense of security in the test results.
How Do I Test?

The most common tools for Listeria testing are swabs and sponges. Swabs are typically used for food contact surfaces of tighter, hard to reach positions. Sponges are typically used for non-food contact surfaces such as walls and drains. Either can be used throughout the facility.
Always ask the laboratory for sampling procedures. Each test result is based on a certain surface area. The area that the sample is pulled from should reflect this. A common issue is that samples are pulled from a much smaller surface area than the test result expects.
Sponges are usually sampled from a 3 feet by 3 feet area. Swabs are usually sampled from 5 separate 8 inch by 1 inch areas from the same line/environmental area.
When sampling drains with a sponge, this would mean sampling the interior of the drain, the cover/grate and the area surrounding the drain to get the 3 foot by 3 foot area.
How Is It Found?
Laboratories can normally detect listeria on samples via cultural methods or rapid detection methods (i.e. PCR or RNA detection). Cultural detection methods involve trying to grow the bacteria on media while rapid detection looks for the DNA or RNA of the bacteria.
With culturing the bacteria, a positive result can only be found if the listeria is growing on the media (i.e. it is alive). Rapid detection methods are looking for the presence of genetic material; the bacteria could be dead or alive.
What do the Results Mean?
Laboratories generally give results as “presumptive positive” or “positive”.
Under normal circumstance, presumptive positive means that listeria has been detected on a given sample. This does not indicate if it is living or dead. This test usually takes 24-48 hours (using rapid detection methods not cultural).
At this point, the laboratory usually gives the option to culture the sample to determine whether the listeria is alive and if it is which species. It takes 2 to 8 days to culture a sample following USDA/FDA BAM guidelines. After culturing, if the sample has been confirmed “positive” it means that listeria is alive on that sample.
Some laboratories allow the choice of only culturing a sample and not using any rapid detection. This would typically take 72 hours to get negative results or up to 8 days to get a positive result.
Depending on the reason for the testing, a presumptive positive result may be enough. It is not always necessary to culture a sample.
What Should I Do?

Regardless of whether a result is presumptive positive or positive, there is still an issue which needs to be investigated. Listeria was present in the facility at some point in time.
This is also true if the sample was cultured and found that it was not L. mono. Listeria species all grow in similar environments. Just because L. mono was not found in a single sample does not mean that there is not a serious problem.
Remember a positive result is a positive result and should not be discarded or ignored.
So what to do…
Step 1 – Stop and investigate
Step 2 – Correct the identified risk areas
Step 3 – Clean and sanitize
Step 4 – Re-test
The first thing to do when getting an abnormal result is to STOP. Immediately re-testing is not the best course of action. Investigate to see why the result was positive. Results could be positive due to a variety of reasons:
- Breakdown in cleaning/sanitizing program
- Cross-contamination from equipment use (for example, indoor/outdoor forklifts)
- Unsanitary equipment design (cracks/crevices, sandwich joints, poor welds, etc.)
- Inadequate drainage systems
Until an issue’s source has been identified it will continue to be a problem. Use microbiological re-testing as a verification tool to ensure that the problem has been correctly identified and remediated.
Final Thoughts
Listeria is more of a pathogen of concern for the produce industry than previously thought. The recent bout of recalls and outbreaks concerning listeria in produce seems to confirm this. Being proactive in testing can be a valuable tool in detecting its presence.
For more information, questions or consulting services please contact Katie Odrobina directly at 706-881-0092, kodrobina@producefoodsafetyservices.com or visit the website at http://www.producefoodsafetyservices.com/.[/textblock][/column][/row]